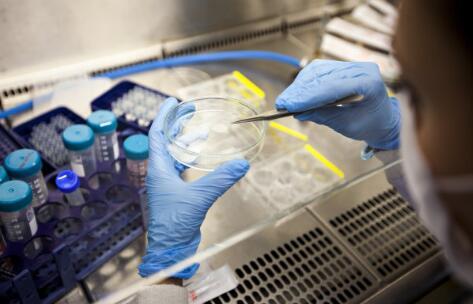

河源上户口司法亲子鉴定多少钱一次?
河源亲子鉴定可以咨询致源基因亲子鉴定中心!具有国家颁发的专业资质,并拥有独立的实验室空间,采用国家先进的DNA分析技术,鉴定正确率高达100%
服务范围:北京、上海、广东、深圳、河源、湖北、江苏、湖南、河源、福建、天津、河源等300多个城市
咨询范围:河源个人隐私亲子鉴定、河源无创胎儿亲子鉴定、河源司法亲子鉴定咨询预约、河源上户口亲子鉴定、河源儿童基因身份鉴定、河源入学亲子鉴定、河源成人亲子鉴定、河源宝宝亲子鉴定等其他基因检测
受理范围:司法亲子鉴定,落户亲子鉴定,上户口亲子鉴定,个人亲子鉴定,隐私亲子鉴定,匿名亲子鉴定,产前亲子鉴定,孕期亲子鉴定,无创胎儿亲子鉴定,旁系亲缘鉴定,升学亲子鉴定等
在河源对于非婚生子女、超生子女、无出生证、被拐卖后找回等情况。在申报户口时规定了需要做亲子鉴定的亲子鉴定类型属于司法亲子鉴定
河源办理申报户口的亲子鉴定时一定要注意的问题:
1、咨询户籍部门,亲子鉴定需要几个人做?
2、需要在报告中附上什么证件?
河源上户口亲子鉴定办理流程:
上户口亲子鉴定属于上户关系人自行证明亲子关系的过程,因而鉴定证明仅需鉴定当事人提供:
1、能够证明被鉴定人身份的证明:如身份证、户口本、军人身份证明、出生证明等。无以上证明者就需要乡镇以上人民政府、街道办、公安派出所申请鉴定证明。
2、被鉴定人必须到司法鉴定中心采血参加鉴定,并完成身份验证工作。主要验证身份证明、留指纹、照相。
全部流程按照司法局要求公开、公正。公平的原则
河源上户口亲子鉴定多少钱一次?
司法亲子鉴定单亲2人2400元-3600元,双亲三人3000元-4600元
每个地方的收费会有差异,正常情况需要父母子三人做,但如果是落户某一位名下,也可以鉴定两人
河源上户口亲子鉴定的费用是通过鉴定人数、鉴定周期来收取的,出报告的时间一般为实验室收到样本后 (从收到样本第二天算起)三到五个工作日,加急的话,需要另外收加急费,也就是鉴定周期
在河源做上户口亲子鉴定必须注意,鉴定报告一定要有法律效力,被公检法认可的,一定要找正规的司法鉴定中心做,谨慎识别,避免鉴定报告无法使用。
一、河源市正规亲子鉴定中心地址信息一览:
1、河源正城司法鉴定所
机构地址:河源渝南大道239号附4号
2.河源大学司法鉴定中心
机构地址:河源渝南大道旭辉城
3.河源汉博司法鉴定中心
机构地址:河源渝南大道旭辉城
4.河源华硕司法鉴定中心
机构地址:河源瑞龙路233号附364号(旭辉城)
5.河源真麦司法鉴定中心
机构地址:河源瑞龙路233号附364号
6.金致源安司法鉴定中心
机构地址:河源河源德普外国语学校南门东侧约90米
7.河源明皓司法鉴定所
机构地址:河源盛龙路1390号中交锦悦御蓝湾
8.河源辉跃司法鉴定所
机构地址:河源龙洲湾街道瑞龙路16号
9.河源精神病学司法鉴定所
机构地址:河源渝南大道233号附309号
10.河源发展司法鉴定所
机构地址:河源渝南大道旭辉城一期233号附277号
以上数据来源于互联网,如有侵权请联系删除。声明:本文机构信息来源于国家司法鉴定名录网,为读者提供更多信息咨询,所涉内容不构成办理、咨询建议;任何单位或个人认为文章内容涉嫌侵犯其合法权益的,可以及时留言,提供相关证明材料和理由,收到后采取相应措施。
热门阅读
-
 河北一男子给孩子上户口,被告知要做亲子鉴定?? 2023-3-15 16:43:55
河北一男子给孩子上户口,被告知要做亲子鉴定?? 2023-3-15 16:43:55 -
 在河北个人亲子鉴定怎么做呢? 2023-3-20 10:56:58
在河北个人亲子鉴定怎么做呢? 2023-3-20 10:56:58 -
 男朋友不承认孩子是他的怎么办? 2023-3-21 10:43:41
男朋友不承认孩子是他的怎么办? 2023-3-21 10:43:41 -
 亲子鉴定师:做过2万家庭亲子鉴定,28%鉴定为“不是亲生” 2023-3-23 9:50:36
亲子鉴定师:做过2万家庭亲子鉴定,28%鉴定为“不是亲生” 2023-3-23 9:50:36 -
 发现女儿的血型很奇怪,是不是要做个亲子鉴定? 2023-3-24 9:41:04
发现女儿的血型很奇怪,是不是要做个亲子鉴定? 2023-3-24 9:41:04 -
 河北亲子鉴定多少钱一次【附2023最低收费标准】 2023-5-22 11:46:27
河北亲子鉴定多少钱一次【附2023最低收费标准】 2023-5-22 11:46:27 -
 河北哪里可以做亲子鉴定(2023河北亲子鉴定机构地址大全) 2023-4-24 15:32:47
河北哪里可以做亲子鉴定(2023河北亲子鉴定机构地址大全) 2023-4-24 15:32:47 -
 河北做亲子鉴定一般需要多少钱? 2023-6-12 10:06:45
河北做亲子鉴定一般需要多少钱? 2023-6-12 10:06:45


